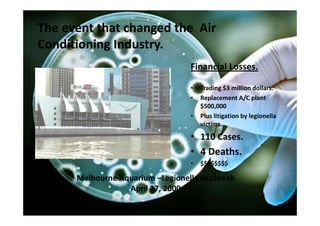
The event that changed the  Air 
Conditioning Industry.  
                                  Financial Losses.

                                  •   Trading $3 million dollars.
                                  •   Replacement A/C plant 
                                      $500,000
                                  •   Plus litigation by legionella  
                                      victims.
                                  • 110 Cases.
                                  • 4 Deaths.
                                  •   $$$$$$$$

      Melbourne Aquarium –Legionella Outbreak
                  April 27, 2000
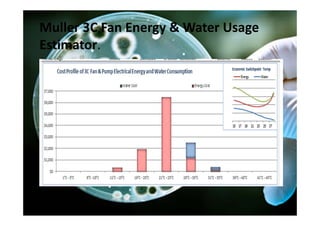
Muller 3C Fan Energy & Water Usage 
Estimator.

The document presents a case study on using an alternative cooling system called the Muller 3C at Austin Hospital as a safer and more efficient replacement for conventional cooling towers, highlighting issues with cooling towers like health and safety risks, high water and chemical usage, and business risks, and how the Muller 3C solution provides benefits like reduced water and chemical usage, lower risks, and potential cost savings.